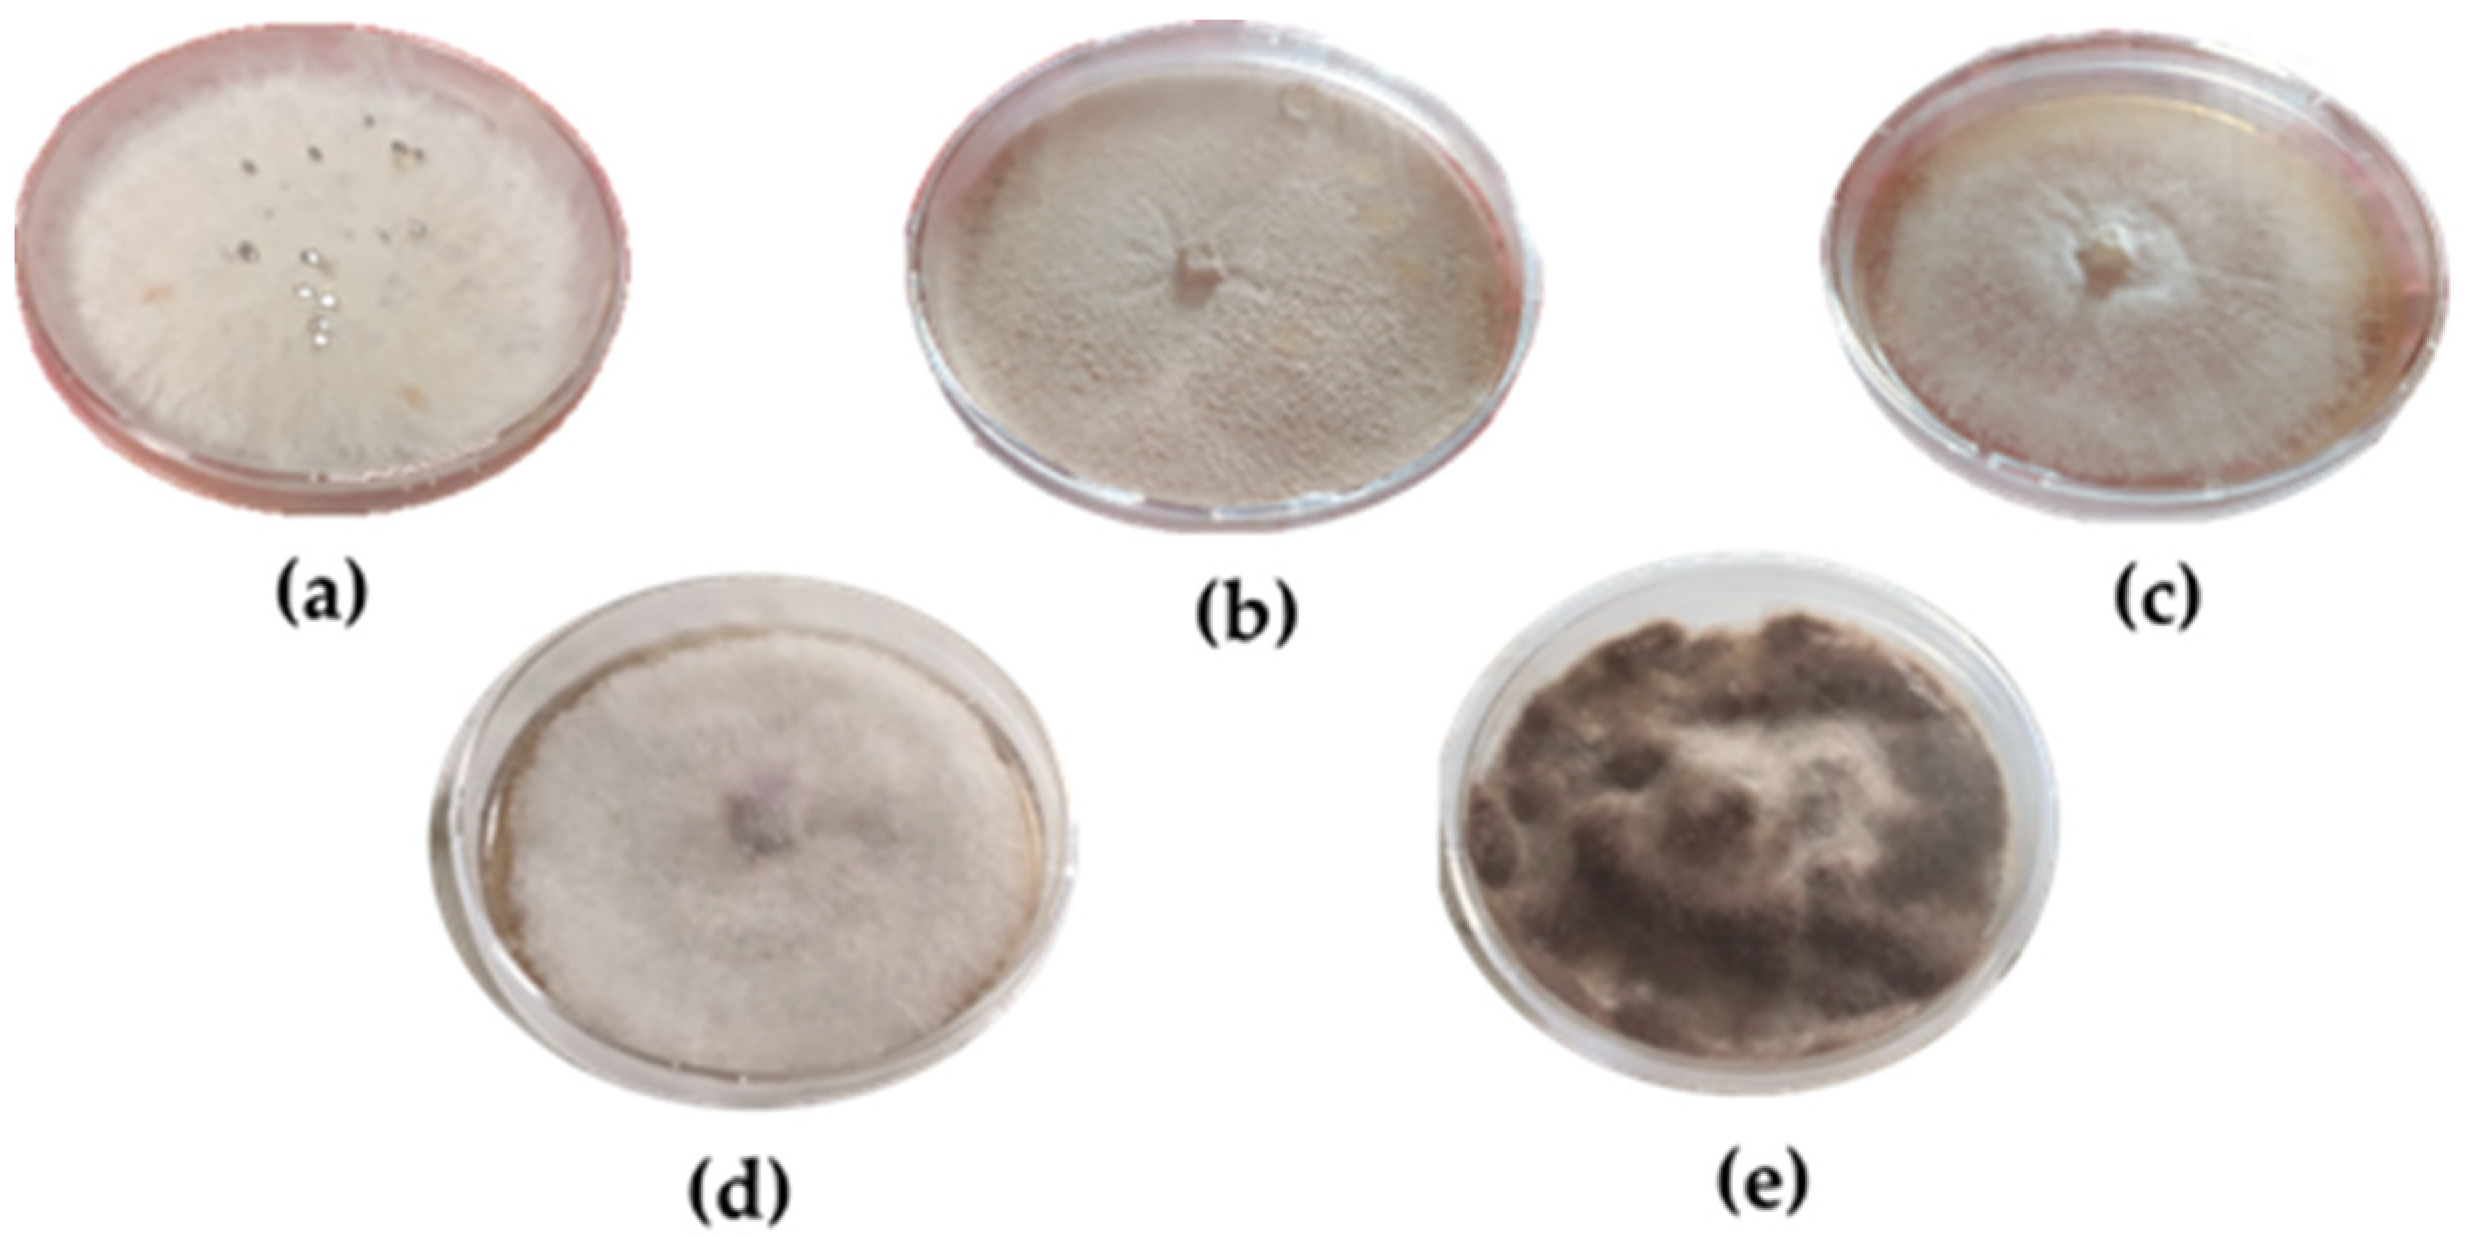

Chemical Profiles, In Vitro Antioxidant and Antifungal Activity of Four Different Lavandula angustifolia L. EOs
Abstract
1. Introduction
2. Results
2.1. EO Yield and Composition
2.2. Explorative Data Analysis
2.3. Antifungal In Vitro Test
2.4. Antioxidant Assay
2.5. Case Study
2.5.1. Historical Work of Art: Timber of Wood Dated 1876
2.5.2. Microbial Counts–Growth on Sample Surfaces Was Analyzed
3. Discussion
4. Materials and Methods
4.1. Plant Materials
4.2. EOs Isolation
4.3. GC-FID Analysis and GC/MS Analysis
4.4. Identification of EO Components
4.5. Statistical Analysis
4.6. Antifungal Activity Assay
4.7. Antioxidant Activity
4.8. Case Study
4.8.1. Sampling, Samples and Microbial Growth
4.8.2. Isolation and Characterization Procedures
5. Conclusions
Supplementary Materials
Author Contributions
Funding
Institutional Review Board Statement
Informed Consent Statement
Data Availability Statement
Acknowledgments
Conflicts of Interest
Sample Availability
References
- Butnariu, M.; Sarac, I. Essential Oils from Plants. J. Biotechnol. Biomed. Sci. 2018, 1, 35–43. [Google Scholar] [CrossRef]
- Zheljazkov, V.D.; Cantrell, C.L.; Astatkie, T.; Jeliazkova, E. Distillation Time Effect on Lavender Essential Oil Yield and Composition. J. Oleo Sci. 2013, 62, 195–199. [Google Scholar] [CrossRef] [PubMed]
- Kiran Babu, G.D.; Sharma, A.; Singh, B. Volatile Composition of Lavandula angustifolia Produced by Different Extraction Techniques. J. Essent. Oil Res. 2016, 28, 489–500. [Google Scholar] [CrossRef]
- Rathore, S.; Kumar, R. Essential Oil Content and Compositional Variability of Lavandula Species Cultivated in the Mid Hill Conditions of the Western Himalaya. Molecules 2022, 27, 3391. [Google Scholar] [CrossRef] [PubMed]
- Fierascu, R.C.; Fierascu, I.C.; Dinu-Pirvu, C.E.; Fierascu, I.; Paunescu, A. The Application of Essential Oils as a Next-Generation of Pesticides: Recent Developments and Future Perspectives. Z. Für Naturforsch. C 2020, 75, 183–204. [Google Scholar] [CrossRef] [PubMed]
- Senthil-Nathan, S. A Review of Resistance Mechanisms of Synthetic Insecticides and Botanicals, Phytochemicals, and Essential Oils as Alternative Larvicidal Agents Against Mosquitoes. Front. Physiol. 2020, 10, 1591. [Google Scholar] [CrossRef]
- Abd-ElGawad, A.M.; El Gendy, A.E.-N.G.; Assaeed, A.M.; Al-Rowaily, S.L.; Omer, E.A.; Dar, B.A.; Al-Taisan, W.A.; Elshamy, A.I. Essential Oil Enriched with Oxygenated Constituents from Invasive Plant Argemone Ochroleuca Exhibited Potent Phytotoxic Effects. Plants 2020, 9, 998. [Google Scholar] [CrossRef]
- Walia, S.; Kumar, R. Wild Marigold (Tagetes Minuta L.) Biomass and Essential Oil Composition Modulated by Weed Management Techniques. Ind. Crops Prod. 2021, 161, 113183. [Google Scholar] [CrossRef]
- Donelli, D.; Antonelli, M.; Bellinazzi, C.; Gensini, G.F.; Firenzuoli, F. Effects of Lavender on Anxiety: A Systematic Review and Meta-Analysis. Phytomedicine 2019, 65, 153099. [Google Scholar] [CrossRef]
- Nazzaro, F.; Fratianni, F.; De Martino, L.; Coppola, R.; De Feo, V. Effect of Essential Oils on Pathogenic Bacteria. Pharmaceuticals 2013, 6, 1451–1474. [Google Scholar] [CrossRef]
- Benabdelkader, T.; Zitouni, A.; Guitton, Y.; Jullien, F.; Maitre, D.; Casabianca, H.; Legendre, L.; Kameli, A. Essential Oils from Wild Populations of Algerian Lavandula stoechas L.: Composition, Chemical Variability, and in vitro Biological Properties. Chem. Biodivers. 2011, 8, 937–953. [Google Scholar] [CrossRef] [PubMed]
- Kıvrak, Ş. Essential Oil Composition and Antioxidant Activities of Eight Cultivars of Lavender and Lavandin from Western Anatolia. Ind. Crops Prod. 2018, 117, 88–96. [Google Scholar] [CrossRef]
- Lesage-Meessen, L.; Bou, M.; Sigoillot, J.-C.; Faulds, C.B.; Lomascolo, A. Essential Oils and Distilled Straws of Lavender and Lavandin: A Review of Current Use and Potential Application in White Biotechnology. Appl. Microbiol. Biotechnol. 2015, 99, 3375–3385. [Google Scholar] [CrossRef] [PubMed]
- Report, G.E.O.M. Essential Oils Market—Global Forecast to 2025. Available online: https://www.marketsandmarkets.com/pdfdownloadNew.asp?id=119674487 (accessed on 22 December 2021).
- Baydar, H.; Kineci, S. Scent Composition of Essential Oil, Concrete, Absolute and Hydrosol from Lavandin ( Lavandula × Intermedia Emeric Ex Loisel.). J. Essent. Oil Bear. Plants 2009, 12, 131–136. [Google Scholar] [CrossRef]
- ISO 8902:2009—Oil of Lavandin Grosso (Lavandula angustifolia Mill. × Lavandula latifolia Medik.), French Type. 2009.
- Białoń, M.; Krzyśko-Łupicka, T.; Nowakowska-Bogdan, E.; Wieczorek, P.P. Chemical Composition of Two Different Lavender Essential Oils and Their Effect on Facial Skin Microbiota. Molecules 2019, 24, 3270. [Google Scholar] [CrossRef]
- Da Porto, C.; Decorti, D.; Kikic, I. Flavour Compounds of Lavandula angustifolia L. to Use in Food Manufacturing: Comparison of Three Different Extraction Methods. Food Chem. 2009, 112, 1072–1078. [Google Scholar] [CrossRef]
- Reverchon, E.; Porta, G.D.; Senatore, F. Supercritical CO2 Extraction and Fractionation of Lavender Essential Oil and Waxes. J. Agric. Food Chem. 1995, 43, 1654–1658. [Google Scholar] [CrossRef]
- Caprari, C.; Fantasma, F.; Divino, F.; Bucci, A.; Iorizzi, M.; Naclerio, G.; Ranalli, G.; Saviano, G. Chemical Profile, In Vitro Biological Activity and Comparison of Essential Oils from Fresh and Dried Flowers of Lavandula angustifolia L. Molecules 2021, 26, 5317. [Google Scholar] [CrossRef]
- Saad, N.Y.; Muller, C.D.; Lobstein, A. Major Bioactivities and Mechanism of Action of Essential Oils and Their Components. Flavour Fragr. J. 2013, 28, 269–279. [Google Scholar] [CrossRef]
- Popovici, R.; Vaduva, D.; Pinzaru, I.; Dehelean, C.; Farcas, C.; Coricovac, D.; Danciu, C.; Popescu, I.; Alexa, E.; Lazureanu, V.; et al. A Comparative Study on the Biological Activity of Essential Oil and Total Hydro-Alcoholic Extract of Satureja hortensis L. Exp. Ther. Med. 2019, 18, 932–942. [Google Scholar] [CrossRef]
- Arias-Estévez, M.; López-Periago, E.; Martínez-Carballo, E.; Simal-Gándara, J.; Mejuto, J.-C.; García-Río, L. The Mobility and Degradation of Pesticides in Soils and the Pollution of Groundwater Resources. Agric. Ecosyst. Environ. 2008, 123, 247–260. [Google Scholar] [CrossRef]
- Hernández, A.F.; Gil, F.; Lacasaña, M. Toxicological Interactions of Pesticide Mixtures: An Update. Arch. Toxicol. 2017, 91, 3211–3223. [Google Scholar] [CrossRef] [PubMed]
- Marcotte, S.; Estel, L.; Leboucher, S.; Minchin, S. Occurrence of Organic Biocides in the Air and Dust at the Natural History Museum of Rouen, France. J. Cult. Herit. 2014, 15, 68–72. [Google Scholar] [CrossRef]
- Giordano, L. Panoramica Sui Principali Agenti Di Carie Brune. Arbor 2017, 1, 13–18. [Google Scholar]
- Gao, D.; Du, L.; Yang, J.; Wu, W.-M.; Liang, H. A Critical Review of the Application of White Rot Fungus to Environmental Pollution Control. Crit. Rev. Biotechnol. 2010, 30, 70–77. [Google Scholar] [CrossRef] [PubMed]
- Zhou, S.; Raouche, S.; Grisel, S.; Navarro, D.; Sigoillot, J.; Herpoël-Gimbert, I. Solid-state Fermentation in Multi-well Plates to Assess Pretreatment Efficiency of Rot Fungi on Lignocellulose Biomass. Microb. Biotechnol. 2015, 8, 940–949. [Google Scholar] [CrossRef]
- Palla, F.; Caruana, E.; Di Carlo, E.; Rotolo, V. Plant Essential Oils in Controlling Fungal Colonization on Wooden Substrate. Borziana 2021, 2, 5–13. [Google Scholar] [CrossRef]
- Pandey, A.K.; Kumar, P.; Singh, P.; Tripathi, N.N.; Bajpai, V.K. Essential Oils: Sources of Antimicrobials and Food Preservatives. Front. Microbiol. 2017, 7, 2161. [Google Scholar] [CrossRef]
- El Khetabi, A.; Lahlali, R.; Ezrari, S.; Radouane, N.; Lyousfi, N.; Banani, H.; Askarne, L.; Tahiri, A.; El Ghadraoui, L.; Belmalha, S.; et al. Role of Plant Extracts and Essential Oils in Fighting against Postharvest Fruit Pathogens and Extending Fruit Shelf Life: A Review. Trends Food Sci. Technol. 2022, 120, 402–417. [Google Scholar] [CrossRef]
- Adams, R. Identification of Essential Oil Components by Gas Chromatography/Mass Spectrometry; II, C.S., Ed.; Allured Publishing Co.,: Carol Stream, IL, USA, 2007. [Google Scholar]
- Pielou, E.C. Ecological Diversity; Wiley Interscience; John Wiley and Sons: New York, NY, USA, 1975; ISBN 9780471689256. [Google Scholar]
- Ärje, J.; Choi, K.P.; Divino, F.; Meissner, K.; Kärkkäinen, S. Understanding the Statistical Properties of the Percent Model Affinity Index Can Improve Biomonitoring Related Decision Making. Stoch. Environ. Res. Risk Assess. 2016, 30, 1981–2008. [Google Scholar] [CrossRef]
- Vittorini Mannetti, M.P. Percorsi di Uomini Percorsi di Fede Dall’Est a Villa Badessa Immagini Icone Costumi; Menabò: Ortona, Italy, 2012; pp. 138–139. ISBN 8895535030. [Google Scholar]
- Silva, F.; Ferreira, S.; Duarte, A.; Mendonça, D.I.; Domingues, F.C. Antifungal Activity of Coriandrum sativum Essential Oil, Its Mode of Action against candida Species and Potential Synergism with Amphotericin B. Phytomedicine 2011, 19, 42–47. [Google Scholar] [CrossRef] [PubMed]
- Savary, S.; Ficke, A.; Aubertot, J.-N.; Hollier, C. Crop Losses Due to Diseases and Their Implications for Global Food Production Losses and Food Security. Food Secur. 2012, 4, 519–537. [Google Scholar] [CrossRef]
- Fidanza, M.R.; Caneva, G. Natural Biocides for the Conservation of Stone Cultural Heritage: A Review. J. Cult. Herit. 2019, 38, 271–286. [Google Scholar] [CrossRef]
- Oerke, E.-C. Crop Losses to Pests. J. Agric. Sci. 2006, 144, 31–43. [Google Scholar] [CrossRef]
- Wavare, S.H.; Gade, R.M.; Shitole, A.V. Effect of Plant Extracts, Bio Agents and Fungicides against Sclerotium rolfsii Causing Collar Rot in Chickpea. Indian J. Pharm. Sci. 2017, 79, 513–520. [Google Scholar] [CrossRef]
- Pinto, E.; Pina-Vaz, C.; Salgueiro, L.; Gonçalves, M.J.; Costa-de-Oliveira, S.; Cavaleiro, C.; Palmeira, A.; Rodrigues, A.; Martinez-de-Oliveira, J. Antifungal Activity of the Essential Oil of Thymus pulegioides on Candida, Aspergillus and Dermatophyte Species. J. Med. Microbiol. 2006, 55, 1367–1373. [Google Scholar] [CrossRef]
- D’agostino, M.; Tesse, N.; Frippiat, J.P.; Machouart, M.; Debourgogne, A. Essential Oils and Their Natural Active Compounds Presenting Antifungal Properties. Molecules 2019, 24, 3713. [Google Scholar] [CrossRef]
- Krishnaiah, D.; Sarbatly, R.; Nithyanandam, R. A Review of the Antioxidant Potential of Medicinal Plant Species. Food Bioprod. Process. 2011, 89, 217–233. [Google Scholar] [CrossRef]
- Ye, Z.-W.; Zhang, J.; Townsend, D.M.; Tew, K.D. Oxidative Stress, Redox Regulation and Diseases of Cellular Differentiation. Biochim. Biophys. Acta—Gen. Subj. 2015, 1850, 1607–1621. [Google Scholar] [CrossRef]
- Kedare, S.B.; Singh, R.P. Genesis and Development of DPPH Method of Antioxidant Assay. J. Food Sci. Technol. 2011, 48, 412–422. [Google Scholar] [CrossRef]
- Adhikari, L.; Kotiyal, R.; Pandey, M.; Bharkatiya, M.; Sematy, A.; Semalty, M. Effect of Geographical Location and Type of Extract on Total Phenol/Flavon Contents and Antioxidant Activity of Different Fruits Extracts of Withania somnifera. Curr. Drug Discov. Technol. 2020, 17, 92–99. [Google Scholar] [CrossRef]
- Ben Farhat, M.; Sotomayor, J.A.; Jordán, M.J. Antioxidants of Salvia aegyptiaca L. Residues Depending on Geographical Origin. Biocatal. Agric. Biotechnol. 2019, 17, 486–491. [Google Scholar] [CrossRef]
- Okoh, S.O.; Asekun, O.T.; Familoni, O.B.; Afolayan, A.J. Antioxidant and Free Radical Scavenging Capacity of Seed and Shell Essential Oils Extracted from Abrus precatorius (L). Antioxidants 2014, 3, 278–287. [Google Scholar] [CrossRef]
- Sihoglu Tepe, A.; Ozaslan, M. Anti-Alzheimer, Anti-Diabetic, Skin-Whitening, and Antioxidant Activities of the Essential Oil of Cinnamomum zeylanicum. Ind. Crops Prod. 2020, 145, 112069. [Google Scholar] [CrossRef]
- Calo, J.R.; Crandall, P.G.; O’Bryan, C.A.; Ricke, S.C. Essential Oils as Antimicrobials in Food Systems—A Review. Food Control 2015, 54, 111–119. [Google Scholar] [CrossRef]
- Klauke, A.-L.; Racz, I.; Pradier, B.; Markert, A.; Zimmer, A.M.; Gertsch, J.; Zimmer, A. The Cannabinoid CB2 Receptor-Selective Phytocannabinoid Beta-Caryophyllene Exerts Analgesic Effects in Mouse Models of Inflammatory and Neuropathic Pain. Eur. Neuropsychopharmacol. 2014, 24, 608–620. [Google Scholar] [CrossRef]
- Ruberto, G.; Baratta, M.T. Antioxidant Activity of Selected Essential Oil Components in Two Lipid Model Systems. Food Chem. 2000, 69, 167–174. [Google Scholar] [CrossRef]
- Seol, G.-H.; Kang, P.; Lee, H.S.; Seol, G.H. Antioxidant Activity of Linalool in Patients with Carpal Tunnel Syndrome. BMC Neurol. 2016, 16, 17. [Google Scholar] [CrossRef]
- Daferera, D.J.; Ziogas, B.N.; Polissiou, M.G. The Effectiveness of Plant Essential Oils on the Growth of Botrytis cinerea, Fusarium Sp. and Clavibacter michiganensis Subsp. Michiganensis. Crop Prot. 2003, 22, 39–44. [Google Scholar] [CrossRef]
- Diánez, F.; Santos, M.; Parra, C.; Navarro, M.J.; Blanco, R.; Gea, F.J. Screening of Antifungal Activity of 12 Essential Oils against Eight Pathogenic Fungi of Vegetables and Mushroom. Lett. Appl. Microbiol. 2018, 67, 400–410. [Google Scholar] [CrossRef]
- Marchese, A.; Barbieri, R.; Coppo, E.; Orhan, I.E.; Daglia, M.; Nabavi, S.F.; Izadi, M.; Abdollahi, M.; Nabavi, S.M.; Ajami, M. Antimicrobial Activity of Eugenol and Essential Oils Containing Eugenol: A Mechanistic Viewpoint. Crit. Rev. Microbiol. 2017, 43, 668–689. [Google Scholar] [CrossRef]
- Zhang, J.; Ma, S.; Du, S.; Chen, S.; Sun, H. Antifungal Activity of Thymol and Carvacrol against Postharvest Pathogens Botrytis cinerea. J. Food Sci. Technol. 2019, 56, 2611–2620. [Google Scholar] [CrossRef]
- Qu, S.; Yang, K.; Chen, L.; Liu, M.; Geng, Q.; He, X.; Li, Y.; Liu, Y.; Tian, J. Cinnamaldehyde, a Promising Natural Preservative Against Aspergillus flavus. Front. Microbiol. 2019, 10, 2895. [Google Scholar] [CrossRef] [PubMed]
- Mani-López, E.; Cortés-Zavaleta, O.; López-Malo, A. A Review of the Methods Used to Determine the Target Site or the Mechanism of Action of Essential Oils and Their Components against Fungi. SN Appl. Sci. 2021, 3, 44. [Google Scholar] [CrossRef]
- ECHA REACH List. Available online: https://echa.europa.eu/substance-information/-/substanceinfo/100.063.544 (accessed on 23 August 2022).
- Sprocati, A.R.; Alisi, C.; Migliore, G.; Marconi, P.; Tasso, F. Sustainable Restoration Through Biotechnological Processes: A Proof of Concept. In Microorganisms in the Deterioration and Preservation of Cultural Heritage; Joseph, E., Ed.; Springer International Publishing: Cham, Amsterdam, 2021; pp. 235–261. ISBN 978-3-030-69410-4. [Google Scholar]
- Council of Europe. European Pharmacopoeia, 5th ed.; Council of Europe: Strasbourg, France, 2004. [Google Scholar]
- Kováts, E. Gas Chromatographic Characterization of Organic Substances in the Retention Index System. In Advances in Chromatography; Marcel Dekker: New York, NY, USA, 1965; pp. 229–247. [Google Scholar]
- van den Dool, H.; Kratz, P.D. A Generalization of the Retention Index System Including Linear Temperature Programmed Gas-Liquid Par-Tition Chromatography. J. Chromatogr. A. 1963, 11, 463–471. [Google Scholar] [CrossRef] [PubMed]
- Braz, V.S.; Melchior, K.; Moreira, C.G. Escherichia coli as a Multifaceted Pathogenic and Versatile Bacterium. Front. Cell. Infect. Microbiol. 2020, 10, 1–9. [Google Scholar] [CrossRef]
- Xie, C.; Huang, C.H.; Vallad, G.E. Mycelial Compatibility and Pathogenic Diversity among Sclerotium rolfsii Isolates in the Southern United States. Plant Dis. 2014, 98, 1685–1694. [Google Scholar] [CrossRef]
- Hui, L.; He, L.; Huan, L.; Xiaolan, L.; Aiguo, Z. Chemical Composition of Lavender Essential Oil and Its Antioxidant Activity and Inhibition against Rhinitis-Related Bacteria. African J. Microbiol. Res. 2010, 4, 309–313. [Google Scholar]
- Aquilano, C.; Baccari, L.; Caprari, C.; Divino, F.; Fantasma, F.; Saviano, G.; Ranalli, G. Effects of EOs vs. Antibiotics on E. coli Strains Isolated from Drinking Waters of Grazing Animals in the Upper Molise Region, Italy. Molecules 2022, 27, 8177. [Google Scholar] [CrossRef]
- Lorrai, R.; Francocci, F.; Gully, K.; Martens, H.J.; De Lorenzo, G.; Nawrath, C.; Ferrari, S. Impaired Cuticle Functionality and Robust Resistance to Botrytis cinerea in Arabidopsis thaliana Plants with Altered Homogalacturonan Integrity Are Dependent on the Class III Peroxidase AtPRX71. Front. Plant Sci. 2021, 12, 696955. [Google Scholar] [CrossRef]
- Mariotti, L.; Casasoli, M.; Caprari, C.; De Lorenzo, G. A Divergent Polygalacturonase of Fusarium phyllophilum Shows Sequence and Functional Similarity to the Enzyme of F. verticillioides. J. Plant Pathol. 2009, 91, 129–139. [Google Scholar]
- Cook, C.; Devoto, A. Fuel from Plant Cell Walls: Recent Developments in Second Generation Bioethanol Research. J. Sci. Food Agric. 2011, 91, 1729–1732. [Google Scholar] [CrossRef]
- Brand-Williams, W.; Cuvelier, M.E.; Berset, C. Use of a Free Radical Method to Evaluate Antioxidant Activity. LWT—Food Sci. Technol. 1995, 28, 25–30. [Google Scholar] [CrossRef]
- Kıvrak, İ. Analytical Methods Applied to Assess Chemical Composition, Nutritional Value and In vitro Bioactivities of Terfezia olbiensis and Terfezia claveryi from Turkey. Food Anal. Methods 2015, 8, 1279–1293. [Google Scholar] [CrossRef]
- Abrusci, C.; Martín-González, A.; Del Amo, A.; Catalina, F.; Collado, J.; Platas, G. Isolation and Identification of Bacteria and Fungi from Cinematographic Films. Int. Biodeterior. Biodegradation 2005, 56, 58–68. [Google Scholar] [CrossRef]
- Ranalli, G.; Andreotti, A.; Colombini, M.P.; Corti, C.; Lima, G.; Rampazzi, L.; Saviano, G.; Vitullo, D.; Palmieri, D.; Zanardini, E. Biodeterioration of Carbographic Ribbon: Isolation, Identification of Causal Agents and Forensic Implications. J. Appl. Microbiol. 2022, 133, 1843–1856. [Google Scholar] [CrossRef]

| N. | Compound | Exp RI | Ref RI | Area % ± SD LaCC | Area % ± SD LaPE | Area % ± SD LaPS | Area % ± SD LaPRV | Abbr. |
|---|---|---|---|---|---|---|---|---|
| 1 | Tricyclene | 922 | 926 | - | 0.03 ± 0.01 | 0.04 ± 0.01 | 0.02 ± 0.01 | BM |
| 2 | α-Thujene | 929 | 930 | 0.06 ± 0.01 | 0.19 ± 0.03 | 0.25 ± 0.01 | 0.05 ± 0.01 | BM |
| 3 | α-Pinene | 936 | 939 | 0.22 ± 0.01 | 1.26 ± 0.07 | 1.14 ± 0.02 | 0.36 ± 0.02 | BM |
| 4 | Camphene | 950 | 954 | 0.03 ± 0.01 | 0.69 ± 0.04 | 0.81 ± 0.02 | 0.5 ± 0.01 | BM |
| 5 | Sabinene | 976 | 975 | 0.06 ± 0.01 | 0.47 ± 0.07 | 0.25 ± 0.05 | 0.08 ± 0.03 | BM |
| 6 | β-Pinene | 977 | 979 | 0.22 ± 0.03 | 1.18 ± 0.01 | 0.57 ± 0.04 | 0.25 ± 0.06 | BM |
| 7 | 1-Octen-3-ol | 984 | 979 | 0.04 ± 0.01 | 0.16 ± 0.01 | 0.18 ± 0.01 | 0.03 ± 0.01 | OT |
| 8 | 3-Octanone | 990 | 983 | 0.75 ± 0.03 | 0.08 ± 0.01 | 0.13 ± 0.01 | 0.11 ± 0.01 | OT |
| 9 | Myrcene | 993 | 990 | 0.78 ± 0.06 | 0.79 ± 0.02 | 0.58 ± 0.02 | 0.96 ± 0.05 | AM |
| 10 | Butyl butanoate | 999 | 994 | 0.26 ± 0.03 | 0.03 ± 0.01 | 0.03 ± 0.01 | 0.03 ± 0.01 | OT |
| 11 | α-Phellandrene | 1001 | 1002 | - | 0.09 ± 0.01 | 0.08 ± 0.01 | 0.02 ± 0.01 | MM |
| 12 | 3-Carene | 1008 | 1011 | 0.06 ± 0.01 | 0.12 ± 0.01 | 0.12 ± 0.01 | 0.07 ± 0.01 | BM |
| 13 | α-Terpinene | 1016 | 1017 | 0.06 ± 0.02 | 0.13 ± 0.01 | 0.14 ± 0.02 | 0.06 ± 0.01 | MM |
| 14 | 3-Undecen-1-yne | 1018 | 1120 | 0.13 ± 0.01 | 0.09 ± 0.02 | 0.1 ± 0.01 | 0.14 ± 0.01 | OT |
| 15 | p-Cymene | 1025 | 1024 | 0.38 ± 0.01 | 0.19 ± 0.02 | 0.26 ± 0.02 | 0.1 ± 0.01 | MM |
| 16 | Limonene | 1030 | 1029 | 0.25 ± 0.02 | 3.83 ± 0.41 | 3.43 ± 0.14 | 0.75 ± 0.03 | MM |
| 17 | 1,8-Cineole | 1032 | 1031 | 1.18 ± 0.08 | 13.48 ± 0.44 | 7.0 ± 0.12 | 4.26 ± 0.1 | BMO |
| 18 | (Z)-β-Ocimene | 1042 | 1037 | 1.72 ± 0.04 | 1.7 ± 0.27 | 1.94 ± 0.06 | 0.91 ± 0.04 | AM |
| 19 | (E)-β-Ocimene | 1053 | 1050 | 3.45 ± 0.05 | 1.06 ± 0.01 | 1.31 ± 0.04 | 0.91 ± 0.02 | AM |
| 20 | γ-Terpinene | 1061 | 1059 | 0.14 ± 0.02 | 0.41 ± 0.01 | 0.43 ± 0.02 | 0.12 ± 0.01 | MM |
| 21 | cis-Sabinene hydrate | 1070 | 1070 | 0.19 ± 0.02 | 0.47 ± 0.04 | 0.21 ± 0.01 | - | BMO |
| 22 | U | 1076 | - | 0.46 ± 0.01 | 0.17 ± 0.09 | 0.14 ± 0.02 | - | - |
| 23 | Terpinolene | 1089 | 1088 | 0.11 ± 0.01 | 0.63 ± 0.03 | 0.54 ± 0.01 | 0.43 ± 0.02 | MM |
| 24 | Linalool | 1107 | 1096 | 34.6 ± 0.43 | 33.54 ± 0.21 | 39.73 ± 0.43 | 30.02 ± 0.26 | AMO |
| 25 | Octen-3-yl acetate | 1119 | 1112 | 0.73 ± 0.01 | - | - | 0.35 ± 0.01 | OT |
| 26 | allo-Ocimene | 1133 | 1132 | 0.5 ± 0.11 | 0.34 ± 0.33 | 0.33 ± 0.09 | 0.19 ± 0.04 | AM |
| 27 | trans-Pinocarveol | 1141 | 1139 | 0.07 ± 0.02 | 0.02 ± 0 | - | - | BMO |
| 28 | Camphor | 1147 | 1146 | 0.47 ± 0.01 | 5.68 ± 0.1 | 3.87 ± 0.03 | 6.2 ± 0.03 | BMO |
| 29 | Borneol | 1169 | 1169 | 1.05 ± 0.02 | 13.65 ± 0.18 | 16.83 ± 0.34 | 4.43 ± 0.07 | BMO |
| 30 | Lavandulol | 1173 | 1169 | 1.98 ± 0.04 | 0.27 ± 0.02 | - | 0.29 ± 0.08 | AMO |
| 31 | Terpinen-4-ol | 1180 | 1177 | 5.42 ± 0.02 | 8.2 ± 0.16 | 9.98 ± 0.06 | 1.25 ± 0.01 | MMO |
| 32 | α-Terpineol | 1192 | 1188 | 0.88 ± 0.02 | 1.48 ± 0.03 | 0.86 ± 0.06 | 1.61 ± 0.05 | MMO |
| 33 | Hexyl butanoate | 1194 | 1192 | 0.51 ± 0.04 | 0.85 ± 0.03 | 0.75 ± 0.07 | 0.27 ± 0.02 | OT |
| 34 | Estragole (Metil chavicol) | 1198 | 1198 | 0.04 ± 0.04 | 0.06 ± 0.08 | 0.03 ± 0.03 | - | OT |
| 35 | Isobornyl formate | 1229 | 1239 | 0.15 ± 0.05 | 0.22 ± 0.01 | 0.28 ± 0.01 | 0.16 ± 0.03 | OT |
| 36 | Nerol | 1230 | 1229 | 0.13 ± 0.01 | - | - | 0.3 ± 0.01 | AMO |
| 37 | Hexyl-2-metil butyrate | 1241 | 1236 | - | 0.31 ± 0.03 | 0.23 ± 0.01 | 0.03 ± 0.01 | OT |
| 38 | Cumin aldehyde | 1241 | 1241 | 0.14 ± 0.02 | 0.13 ± 0.01 | 0.1 ± 0.01 | 0.08 ± 0.02 | MMO |
| 39 | Hexyl isovalerate | 1246 | 1244 | - | 0.08 ± 0.01 | 0.07 ± 0.01 | 0.14 ± 0.01 | OT |
| 40 | Linalyl acetate | 1265 | 1257 | 24.34 ± 0.34 | 1.8 ± 0.1 | 2.41 ± 0.05 | 31.07 ± 0.13 | AMO |
| 41 | Bornyl acetate | 1289 | 1288 | 0.04 ± 0.01 | 0.06 ± 0.01 | 0.05 ± 0.01 | 0.1 ± 0 | BMO |
| 42 | Lavandulyl acetate | 1296 | 1290 | 6.51 ± 0.02 | 0.49 ± 0.01 | 0.98 ± 0.01 | 3.2 ± 0.03 | AMO |
| 43 | Hexyl tiglate | 1334 | 1332 | 0.07 ± 0.01 | 0.25 ± 0.01 | 0.17 ± 0.01 | 0.1 ± 0 | OT |
| 44 | Eugenol | 1351 | 1359 | 0.2 ± 0.02 | 0.03 ± 0.03 | 0.01 ± 0.01 | 0.02 ± 0 | OT |
| 45 | Neryl acetate | 1368 | 1361 | 0.45 ± 0.02 | 0.06 ± 0.01 | 0.07 ± 0.01 | 0.96 ± 0.03 | AMO |
| 46 | Copaene | 1377 | 1376 | 0.05 ± 0.01 | - | - | - | BS |
| 47 | Daucene | 1380 | 1381 | - | 0.01 ± 0 | - | 0.04 ± 0.01 | BS |
| 48 | β-Bourbonene | 1381 | 1388 | 0.49 ± 0.01 | - | - | - | BS |
| 49 | trans-Myrtanol acetate | 1384 | 1386 | 0.78 ± 0.05 | 0.08 ± 0.01 | 0.1 ± 0.01 | 1.72 ± 0.06 | MMO |
| 50 | Hexyl hexanoate | 1386 | 1383 | 0.15 ± 0.01 | 0.19 ± 0.01 | 0.16 ± 0.02 | - | OT |
| 51 | 7-epi-Sesquithujene | 1391 | 1391 | - | 0.1 ± 0.01 | 0.06 ± 0.01 | - | MSO |
| 52 | Sesquithujene | 1406 | 1405 | 0.01 ± 0 | 0.05 ± 0 | 0.05 ± 0 | 0.02 ± 0 | MSO |
| 53 | Longifolene | 1408 | 1407 | - | 0.01 ± 0 | - | - | BSO |
| 54 | (E)-Caryophyllene | 1420 | 1419 | 2.78 ± 0.04 | 0.26 ± 0.01 | 0.21 ± 0.01 | 0.63 ± 0.02 | BS |
| 55 | Linalyl butanoate | 1426 | 1423 | - | 0.03 ± 0 | 0.03 ± 0 | 0.04 ± 0.01 | AMO |
| 56 | β-Copaene | 1429 | 1432 | 0.07 ± 0.01 | - | - | - | BS |
| 57 | trans-α-Bergamotene | 1436 | 1434 | 0.21 ± 0.01 | 0.04 ± 0 | 0.03 ± 0.01 | 0.04 ± 0.01 | MS |
| 58 | Aromadendrene | 1445 | 1441 | 0.06 ± 0 | 0.03 ± 0.01 | 0.02 ± 0.01 | 0.02 ± 0.01 | BS |
| 59 | epi-β-Santalene | 1448 | 1447 | 0.04 ± 0.01 | - | - | - | MS |
| 60 | α-Humulene | 1454 | 1454 | 0.07 ± 0.01 | 0.01 ± 0 | - | 0.02 ± 0.01 | MS |
| 61 | (E)-β-Farnesene | 1458 | 1456 | 0.33 ± 0.01 | 1.99 ± 0.04 | 1.61 ± 0.01 | 0.33 ± 0.01 | AS |
| 62 | 9-epi-(E)-Caryophyllene | 1463 | 1466 | - | - | - | 0.01 ± 0.01 | BS |
| 63 | Linalyl isovalerate | 1467 | 1468 | - | 0.06 ± 0.01 | 0.06 ± 0.01 | 0.06 ± 0 | ASO |
| 64 | Dauca-5,8-diene | 1469 | 1472 | - | 0.02 ± 0 | - | 0.03 ± 0.01 | BS |
| 65 | γ-Muurolene | 1481 | 1479 | 1.21 ± 0.03 | 0.07 ± 0.01 | 0.08 ± 0.01 | 0.32 ± 0 | BS |
| 66 | α-Amorphene | 1484 | 1484 | 0.07 ± 0.01 | - | - | - | BS |
| 67 | trans-Muurola-4(14),5-diene | 1496 | 1493 | 0.03 ± 0.01 | 0.01 ± 0.01 | - | - | BS |
| 68 | (E)-Methyl isoeugenol | 1500 | 1492 | - | 0.02 ± 0.02 | - | - | OT |
| 69 | (Z)-α-Bisabolene | 1509 | 1507 | 0.05 ± 0.01 | 0.08 ± 0.01 | 0.07 ± 0.01 | 0.06 ± 0.02 | MS |
| 70 | Lavandulyl isovalerate | 1511 | 1509 | - | 0.31 ± 0.01 | 0.23 ± 0.01 | 0.17 ± 0.02 | ASO |
| 71 | γ-Cadinene | 1511 | 1513 | 0.01 ± 0 | 0.03 ± 0.01 | - | 0.17 ± 0.01 | AS |
| 72 | 6-methyl-α-Ionone | 1520 | 1521 | 0.27 ± 0.02 | 0.01 ± 0.01 | - | 0.05 ± 0.02 | OT |
| 73 | δ-Cadinene | 1524 | 1523 | 0.02 ± 0 | 0.02 ± 0 | - | 0.1 ± 0.02 | BS |
| 74 | Spathulenol | 1578 | 1578 | - | - | - | 0.05 ± 0.01 | BSO |
| 75 | Caryophyllene oxide | 1584 | 1583 | 2.84 ± 0.14 | 0.07 ± 0.01 | 0.02 ± 0.01 | 0.55 ± 0.01 | BSO |
| 76 | Guaiol | 1603 | 1600 | - | - | - | 0.04 ± 0.01 | BSO |
| 77 | 1,10-di-epi-Cubenol | 1615 | 1619 | - | - | - | 0.09 ± 0.01 | BSO |
| 78 | α-Muurolol | 1643 | 1646 | - | 0.04 ± 0 | 0.02 ± 0 | 1.73 ± 0.05 | BSO |
| 79 | Bisabolol oxide B | 1657 | 1658 | - | 0.04 ± 0.01 | 0.02 ± 0 | 0.16 ± 0.02 | BSO |
| 80 | Helifolenol A | 1674 | 1675 | 0.23 ± 0.01 | - | - | 0.07 ± 0.01 | BSO |
| 81 | α-Bisabolol | 1686 | 1685 | 0.11 ± 0.02 | 1.23 ± 0.06 | 0.68 ± 0.02 | 2.23 ± 0.12 | MSO |
| Terpenes | Abbreviation | LaCC Area % | LaPE Area % | LaPS Area % | LaPRV Area % |
|---|---|---|---|---|---|
| Aliphatic monoterpenes Monocyclic monoterpenes Bi- and tricyclic monoterpenes | AM MM BM | 6.45 0.94 0.65 | 3.89 5.28 3.94 | 4.16 4.88 3.18 | 2.97 1.48 1.33 |
| Monoterpenes | M | 8.04 | 13.11 | 12.22 | 5.78 |
| Aliphatic monoterpenoids Monocyclic monoterpenoids Bi- and tricyclic monoterpenoids | AMO MMO BMO | 68.01 7.22 3.0 | 36.19 9.89 33.36 | 42.22 11.04 27.96 | 66.51 4.66 14.99 |
| Monoterpenoids | MO | 78.23 | 79.44 | 81.22 | 86.16 |
| Aliphatic sesqiuterpenes Monocyclic sesquiterpenes Bi- and tricyclic sesquiterpenes | AS MS BS | 0.34 0.37 4.78 | 2.02 0.13 0.42 | 1.61 0.1 0.31 | 0.5 0.12 1.15 |
| Sesquiterpes | S | 5.49 | 2.57 | 2.02 | 1.77 |
| Aliphatic sesquiterpenoids Monocyclic sesquiterpenoids Bi- and tricyclic sesquiterpenoids | ASO MSO BSO | - 0.12 3.07 | 0.37 1.38 0.16 | 0.29 0.79 0.06 | 0.23 2.25 2.69 |
| Sesquiterpenoids | SO | 3.19 | 1.91 | 1.14 | 5.17 |
| Others | OT | 3.3 | 2.38 | 2.14 | 1.43 |
| EOs | Similarity | Diversity | ||||
|---|---|---|---|---|---|---|
| LaCC | LaPE | LaPS | LaPRV | Shannon Entropy | Pielou Index | |
| LaCC | 1 | 0.535 ± 0.001 | 0.552 ± 0.001 | 0.719 ± 0.001 | 2.376 ± 0.007 | 0.539 ± 0.002 |
| LaPE | 1 | 0.866 ± 0.001 | 0.592 ± 0.001 | 2.463 ± 0.010 | 0.559 ± 0.002 | |
| LaPS | 1 | 0.565 ± 0.001 | 2.266 ± 0.006 | 0.514 ± 0.001 | ||
| LaPRV | 1 | 2.310 ± 0.007 | 0.524 ± 0.002 | |||
| Sample | IC50 (mg/mL) | % Scavenging Activity |
|---|---|---|
| LaPS | 49.63 ± 0.42 | 13.08–93.04 |
| LaPE | 48.00 ± 0.35 | 28.40–94.24 |
| LaPRV | 33.53 ± 0.23 | 29.98–94.87 |
| LaCC | 26.26 ± 0.21 | 35.29–98.70 |
Disclaimer/Publisher’s Note: The statements, opinions and data contained in all publications are solely those of the individual author(s) and contributor(s) and not of MDPI and/or the editor(s). MDPI and/or the editor(s) disclaim responsibility for any injury to people or property resulting from any ideas, methods, instructions or products referred to in the content. |
© 2023 by the authors. Licensee MDPI, Basel, Switzerland. This article is an open access article distributed under the terms and conditions of the Creative Commons Attribution (CC BY) license (https://creativecommons.org/licenses/by/4.0/).
Share and Cite
Caprari, C.; Fantasma, F.; Monaco, P.; Divino, F.; Iorizzi, M.; Ranalli, G.; Fasano, F.; Saviano, G. Chemical Profiles, In Vitro Antioxidant and Antifungal Activity of Four Different Lavandula angustifolia L. EOs. Molecules 2023, 28, 392. https://doi.org/10.3390/molecules28010392
Caprari C, Fantasma F, Monaco P, Divino F, Iorizzi M, Ranalli G, Fasano F, Saviano G. Chemical Profiles, In Vitro Antioxidant and Antifungal Activity of Four Different Lavandula angustifolia L. EOs. Molecules. 2023; 28(1):392. https://doi.org/10.3390/molecules28010392
Chicago/Turabian StyleCaprari, Claudio, Francesca Fantasma, Pamela Monaco, Fabio Divino, Maria Iorizzi, Giancarlo Ranalli, Fausto Fasano, and Gabriella Saviano. 2023. "Chemical Profiles, In Vitro Antioxidant and Antifungal Activity of Four Different Lavandula angustifolia L. EOs" Molecules 28, no. 1: 392. https://doi.org/10.3390/molecules28010392
APA StyleCaprari, C., Fantasma, F., Monaco, P., Divino, F., Iorizzi, M., Ranalli, G., Fasano, F., & Saviano, G. (2023). Chemical Profiles, In Vitro Antioxidant and Antifungal Activity of Four Different Lavandula angustifolia L. EOs. Molecules, 28(1), 392. https://doi.org/10.3390/molecules28010392







